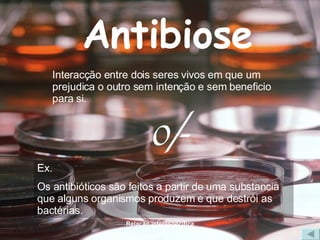
Antibiose Interacção entre dois seres vivos em que um prejudica o outro sem intenção e sem beneficio para si. 0/- Ex. Os antibióticos são feitos a partir de uma substancia que alguns organismos produzem e que destrói as bactérias.

Este documento discute as relações bióticas entre organismos vivos. Ele descreve relações interespecíficas e intra-específicas, incluindo relações harmônicas como mutualismo e simbiose, e relações desarmônicas como parasitismo e competição. Ele fornece exemplos de cada tipo de relação biótica.